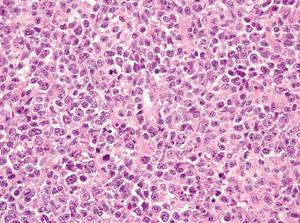
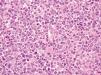
fig3
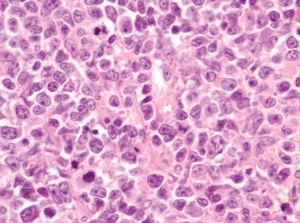
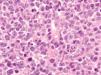
fig4

INTRODUCCION
El linfoma de células grandes B de las piernas (LCCBP) es una proliferación clonal que constituye el 2 % de los linfomas cutáneos primarios. La European Organization for Research and Treatment of Cancer (EORTC) lo incluye dentro de los linfomas de pronóstico intermedio, con una supervivencia media a los 5 años de aproximadamente el 50 al 60 %. Dentro de la clasificación de la OMS se incluiría dentro de los linfomas de células grandes B difusos 1. Este tipo de linfoma se presenta preferentemente en pacientes de edad avanzada, con un ligero predominio en las mujeres. Clínicamente suele cursar clínicamente con nódulos o tumores eritematosos asintomáticos, con frecuencia unilaterales, que suelen asentar en el tercio distal de las piernas 2 y con tendencia a la necrosis. El pronóstico de este tipo de linfomas es intermedio, ya que su supervivencia a los 5 años es de aproximadamente el 50 %. El tratamiento de elección en el caso de lesiones aisladas es la cirugía o la radioterapia. En caso de lesiones múltiples o recidivantes la quimioterapia sería el tratamiento de elección, principalmente con CHOP (ciclofosfamida, adriamicina, vincristina, prednisona). Sin embargo, recientemente se ha empezado a utilizar el rituximab como alternativa terapéutica en este último grupo de pacientes o en casos con pluripatología de base.
Se presenta el caso de un paciente diagnosticado de un LCCBP que presentó remisión completa tras tratamiento con rituximab en infusión intravenosa durante 4 semanas.
DESCRIPCION DEL CASO
Un varón de 77 años que acude a nuestro servicio en junio de 2004 por un cuadro de un mes de evolución consistente en la aparición de una pápula eritematosa asintomática que había aumentado de tamaño rápidamente. Inicialmente se localizaba en la cara interna de la pierna izquierda, pero después habían ido apareciendo nuevas lesiones similares en el muslo y la cara posterior de la misma pierna. Como antecedentes patológicos destacaban hipertensión arterial, hipercolesterolemia, cardiopatía isquémica, accidente cerebrovascular previo sin secuelas, bronquitis crónica e insuficiencia renal crónica. La exploración física mostraba placas y tuberosidades localizadas en la cara interna del muslo izquierdo y en cara interna y posterior de la pierna del mismo lado (fig. 1). Algunas de las placas tenían una morfología arciforme y estaban infiltradas al tacto (fig. 2).
Fig. 1.--Placas eritematosas localizadas en muslo y pierna izquierda.
Fig. 2.--Detalle de una de las placas: se aprecia la morfología anular, la superficie lisa y un nódulo satélite en la periferia.
Se realizaron dos biopsias de las lesiones y el estudio histopatológico mostró un infiltrado masivo multinodular, confluente en dermis superficial que llegaba hasta el tejido celular subcutáneo. La epidermis estaba conservada y se observó la existencia de una banda libre de lesión que separaba el infiltrado linfoide de la epidermis normal.
Dentro del infiltrado, densamente celular, predominaban los linfocitos de tamaño grande con núcleos redondeados, nucléolo excéntrico y cromatina finamente dispersa, que recordaban a los centroblastos; entre ellas se observaban frecuentes figuras de mitosis (fig. 3), así como una población de células de menor tamaño con núcleos más hipercromáticos y contornos más irregulares que corresponderían también a linfocitos aunque su número era menor (fig. 4). Se realizó tinción para CD20 que resultó intensamente positiva en la membrana de las células tumorales. El infiltrado resultó positivo para CD10 y bcl-2, y negativo para CD30 y bcl-6 (figs. 5 y 6).
Fig. 3.--Infiltrado densamente celular en el que predominan los linfocitos de tamaño grande que recuerdan a los centroblastos; entre ellas que se objetivan frecuentes figuras de mitosis. (Hematoxilina-eosina, x200.)
Fig. 4.--Detalle del infiltrado formado principalmente por células grandes de núcleos redondeados y nucléolo excéntrico que recuerdan a centroblastos. Se observan abundantes figuras de mitosis (Hematoxilina-eosina, x400.)
Fig. 5.--Tinción intensamente positiva de las células tumorales para CD-20.
Fig. 6.-- Tinción positiva para bcl-2.
Dentro de los estudios complementarios realizados destacaba una β2-microglobulina de 6.217 (normal, 700-3.500). El estudio de extensión con TC cervicotoracicoabdominopélvica resultó normal, al igual que el aspirado y la biopsia de médula ósea. En sangre periférica y en médula ósea el reordenamiento resultó negativo y el inmunofenotipo normal. En el estudio de reacción en cadena de la polimerasa (PCR) para detección de reordenamiento clonal linfoide sobre material congelado no se detectó reordenamiento de inmunoglobulina H. La determinación de la translocación t(14;18), mediante técnica de hibridación in situ con fluorescencia (FISH) sobre material parafinado, resultó negativa.
Con el diagnóstico clinicopatológico de LCCBP y dada la edad avanzada y la enfermedad de base del paciente, se decidió iniciar tratamiento con rituximab. El rituximab se pautó en infusión intravenosa a una dosis de 375 mg/m 2, una vez a la semana, durante 4 semanas. Como régimen de acondicionamiento se utilizó paracetamol, dexclorfeniramina e hidrocortisona, esta última sólo durante la primera infusión. El paciente sólo presentó ligera astenia y cefalea leve a lo largo del tratamiento. Inmediatamente después de finalizar el tratamiento se apreció que las lesiones tumorales habían desaparecido, dejando una pigmentación residual sin pruebas de infiltración clínica (fig. 5). Tras 6 meses de seguimiento no se han encontrado signos ni síntomas de recidiva tumoral.
COMENTARIOS
Los linfomas cutáneos de células B constituyen el 20-25 % de los linfomas primariamente cutáneos. La gran mayoría de los linfomas cutáneos B son centrofoliculares y linfomas de zona marginal-inmunocitomas. El LCCBP se presenta con mucha menor frecuencia y tiene una presentación y/o comportamiento clínico diferente a las dos entidades previamente citadas. Los LCCBP suelen expresar CD19, CD20, CD22 y CD79a. En nuestro caso la tinción para CD20 resultó intensamente positiva. Un número significativo de linfomas cutáneos difusos, entre los que se incluye el LCCBP, suelen expresar CD10 y/o bcl-6 3. Las células tumorales en nuestro paciente se teñían con CD10 pero no con bcl-6. La expresión del oncogén bcl-2, encontrada con frecuencia en los LCCBP, reduce la supervivencia libre de enfermedad y dota de peor pronóstico a los linfomas que lo expresan frente a los que no lo hacen 4-6. Algunos autores consideran incluso la expresión de la proteína bcl-2 como el factor pronóstico independiente de supervivencia más importante en los linfomas cutáneos de células grandes B 7. La sobreexpresión de la proteína bcl-2 puede resultar de la translocación intercromosómica (14;18) que se observa aproximadamente en el 80 al 100 % de los linfomas foliculares y en el 15 al 20 % de los linfomas difusos de células grandes, aparte de otros mecanismos 5. Se observa con frecuencia sobreexpresión de la proteína bcl-2 en las células grandes de los LCCBP, pero no se suele asociar con t(14;18) 8. La presencia de t(14;18) en un linfoma cutáneo primario suele sugerir la presencia de enfermedad sistémica 9. En el caso que hemos presentado había positividad intensa para bcl-2 pero no se pudo observar la presencia sobre material parafinado de la biopsia de una t(14;18).
El rituximab es un anticuerpo monoclonal quimérico anti-CD20 que presenta dos regiones, una región variable de origen murino que al unirse al CD20 incentiva la apoptosis e inhibe la proliferación celular y una región constante de origen humano IgG1k que activa la respuesta inmunitaria provocando lisis celular mediante citotoxicidad mediada por anticuerpos y complemento 10. El CD20 es una proteína transmembrana hidrofóbica presente en el 100 % de los linfocitos B maduros y en el 90 al 95 % de los linfomas B 11. No se encuentra en las células stem, pro-B ni en las células plasmáticas 12. In vivo provoca una depleción transitoria de linfocitos B en sangre periférica, que se suelen regenerar en el plazo de 6 a 12 meses 13. Las inmunoglobulinas están conservadas, ya que las células plasmáticas no resultan afectadas. La respuesta media de este anticuerpo es de aproximadamente 12 meses, aunque en ocasiones se requieren reinfusiones del mismo para mantener al paciente libre de enfermedad 14. Los efectos secundarios que pueden aparecer a lo largo del tratamiento son generalmente leves y, en el caso de producirse, suelen ceder tras la administración del mismo. Se observan con mayor frecuencia fiebre, escalofríos, náuseas, astenia y cefalea. En menor medida se observan hipotensión, neutropenia y trombocitopenia, entre otros 14. En menos del 1 % de los casos se puede producir una reacción de hipersensibilidad en forma de síndrome de liberación de citocinas, que suele suceder en la primera infusión durante las primeras 2 h. Suele manifestarse con disnea, fiebre, escalofríos, hipotensión, enrojecimiento facial, rigidez, urticaria y angioedema. El tratamiento en estos casos es únicamente sintomático 15. Algunos pacientes refieren dolor punzante en la localización de las lesiones tras la infusión y una reacción urticarial en estas 16. Nuestro paciente presentó astenia y cefalea leve a lo largo del tratamiento principalmente tras la primera infusión.
En la literatura médica se recogen diversos casos de linfomas primariamente cutáneos de células grandes B en las piernas tratados con éxito mediante rituximab en infusión intravenosa 13,16-18.
Hemos presentado un caso de LCCBP en el que se consiguió una remisión de las lesiones tras un ciclo de cuatro infusiones intravenosas de rituximab. La mejoría se produjo de forma notable ya desde la primera infusión, momento desde el cual se observaban lesiones menos infiltradas que progresivamente fueron evolucionando hasta desaparecer completamente. Una pigmentación residual fue lo único que se apreciaba tras el tratamiento completo.
El rituximab ha sido el primer anticuerpo introducido por la Food and Drug Administration (FDA) para el tratamiento de linfomas no hodgkinianos de bajo grado 19. Al igual que se están utilizando nuevas terapias biológicas en el tratamiento de la psoriasis, el rituximab podría considerarse en enfermedades diferentes a los linfomas como el lupus 20 o el pénfigo 21.